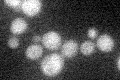
YGL089C
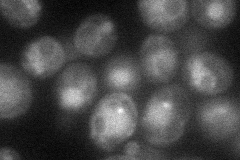
YGL089C
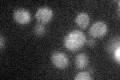
YGL089C

View description
Mating pheromone alpha-factor, made by alpha cells; interacts with mating type a cells to induce cell cycle arrest and other responses leading to mating; also encoded by MF(ALPHA)1, which is more highly expressed than MF(ALPHA)2
Localization:
Intensity:
Fold change:
Significance:
-
C’ GFP library in SD
below threshold18.92 -
N' NOP1pr-GFP in SD
cell periphery,vacuole45.6257 -
N' TEF2pr-mCherry in SD

vacuole15.2642 -
N' NATIVEpr-GFP in SD

missing0 -
N' TEF2pr-VC and Cyto-VN in SD

#N/A0 -
C’ GFP library in SD+DTT

cytosol16.360.86No -
C’ GFP library in SD+H2O2
cytosol18.30.96No -
C’ GFP library in Starvation Media

cytosol16.730.88No -
C’ GFP library on the background of Pup2-DaMP

below threshold -
C’ GFP library on the background of CCT mutant

below threshold15.69470.829062No
